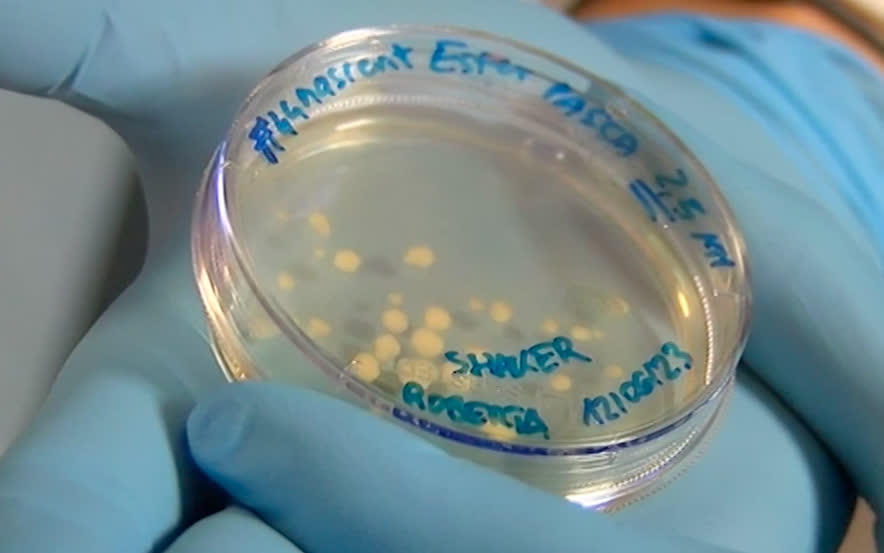

I servizi di TgPadova

VIDEO | Forza Italia passeggia in stazione per la zona rossa
112
14/03/25

VIDEO | Pagate meno e precarie, focus della Cgil sul lavoro delle donne in Veneto
24
14/03/25

VIDEO | In crescita il mercato immobiliare di Padova: “si prospetta un 2025 positivo”
102
14/03/25

VIDEO | Una voragine in strada, sotto Villa Draghi: paura scampata e viabilità modificata
2339
14/03/25
VIDEO | Organi in miniatura per studi e test: a Padova il World Health Forum Veneto
61
14/03/25

VIDEO | Boato all'alba, spaccata alla tabaccheria, oltre 20 mila euro di danni
567
14/03/25

VIDEO | 56 milioni di euro in energia: il piano di Marcato per le imprese venete
25
14/03/25

VIDEO | World Health Forum Veneto: Padova riferimento sanitario internazionale
79
13/03/25

VIDEO | I titoli dell'edizione serale del TgPadova del 13 Marzo
95
13/03/25

VIDEO | Padova Flash, le notizie da tutto il territorio
38
13/03/25

VIDEO | Chiuso il rubinetto d'oro della criminalità: la maxi operazione dei carabinieri
397
13/03/25

VIDEO | "Patrimonio e Benessere": Padova ospiterà la settima edizione di Italian Youth Forum
119
13/03/25

VIDEO | L'ultimo addio a Rino Pinton, l'inventore del Cynar, al Santuario dell'Arcella
262
13/03/25

VIDEO | Stop numero chiuso a medicina: "Il problema è tenere i medici"
336
13/03/25

VIDEO | Anziani, occhio alle truffe!
147
13/03/25

VIDEO | I titoli dell'edizione serale del TgPadova del 12 marzo
80
12/03/25

VIDEO | Padova Flash, le notizie da tutto il territorio
142
12/03/25

VIDEO | "Padova" il nuovo singolo della Testa di Nic è un omaggio alla città
774
12/03/25

VIDEO | Il Sottosegretario di Stato Emanuele Prisco in visita al Comando dei Vigili del Fuoco
59
12/03/25

VIDEO | Suem: Una videochiamata allunga la vita, la tecnologia aiuta i soccorsi
187
12/03/25

VIDEO | L'aggressione a Striscia, le rapine e i soprusi ai coetanei: arrestati due giovanissimi
218
12/03/25
